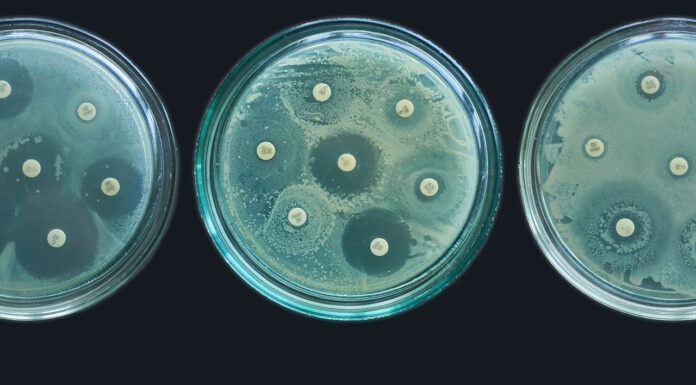

World Pharmacists Day celebrates the pharmacy profession worldwide and amplifies its essential contribution to health systems.
As US regulators flag new warnings on paracetamol use, the TGA and Australian experts have weighed in on what the evidence shows.
A new report lays bare the impact of chronic pain in young people. An expert shares practical steps for pharmacists to improve care.
Pharmacists are asked to lead the shift from reliever to inhaled corticosteroid regimens and to minimise use of oral corticosteroids.
Women of reproductive age using GLP-1 RAs could be at risk of unintended pregnancy, and unaware of the risks to pregnancy and unborn babies.
A blistering session at the FIP Congress challenged policymakers and health professionals to slow the advance of antimicrobial resistance.
New research links methotrexate to a fall in blood pressure. This expert thinks it could lower cardiovascular risk in the general population.
Parents have reported persistent anxiety about asthma attacks. Pharmacists can help to pivot care from treating flare-ups to stopping them.
What ethical lessons do Australian pharmacists need to heed from other countries? A panel of experts at the FIP Congress filled in the blanks.
Medicinal cannabis prescribing in Australia has risen sharply in recent years, with the TGA recording thousands of approvals each month.

AP